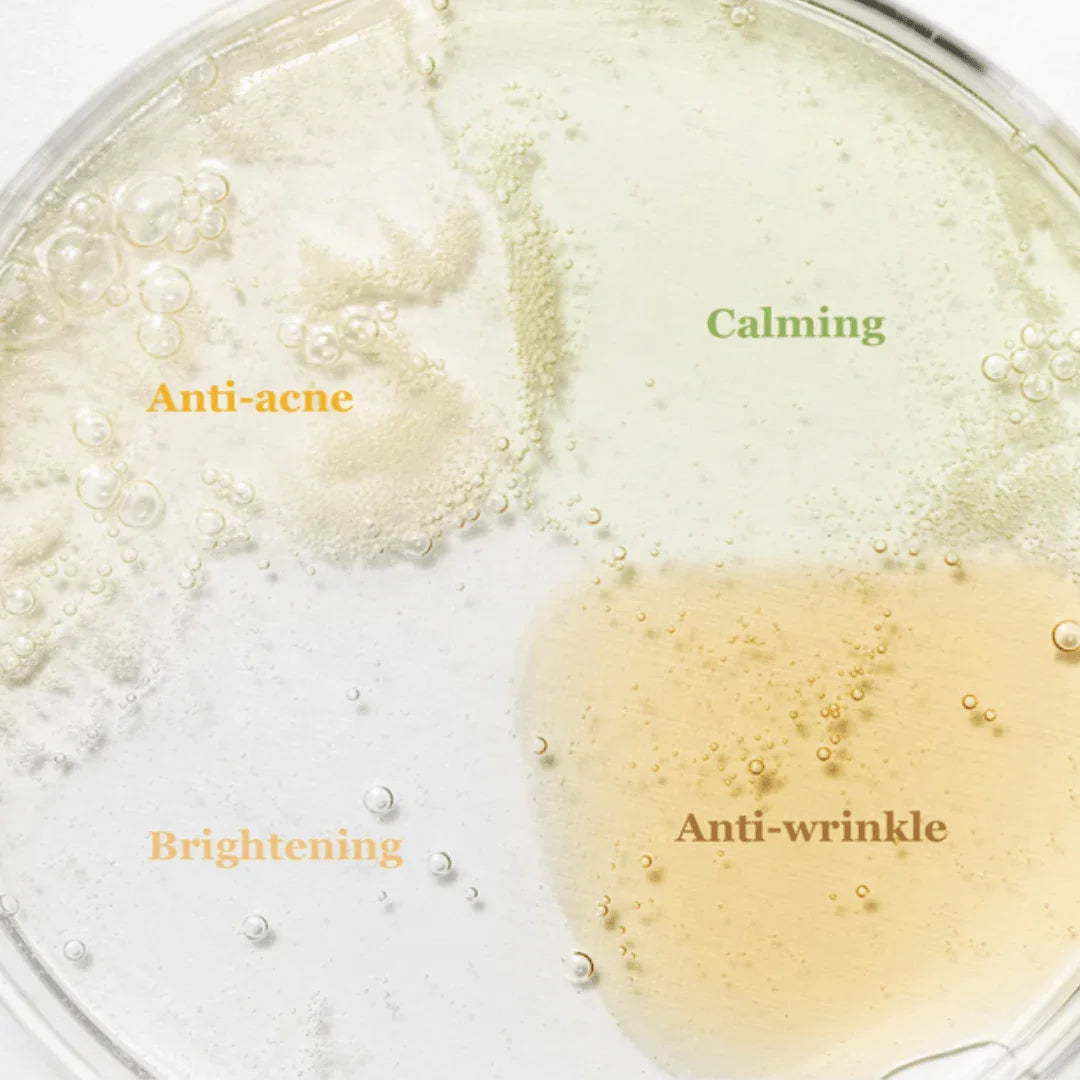
Beauty of JoseonHanbang Serum Discovery KitMood ArabiaIherb

Hanbang Serum Discovery Kit
- Regular price
-
Dhs. 80.00 AED - Regular price
-
Dhs. 100.00 AED - Sale price
-
Dhs. 80.00 AED
What are inside?
Calming Serum : Green Tea + Panthenol (10ml / 0.33fl.oz.)
Glow Serum : Propolis + Niacinamide (10ml / 0.33fl.oz.)
Glow Deep Serum : Rice + Alpha-Arbutin (10ml / 0.33fl.oz.)
Revive Serum : Ginseng + Snail Mucin (10ml / 0.33fl.oz.)
<Calming Serum : Green Tea + Panthenol>
Solution : Green tea leaf water 76% + Panthenol 2%
Notable ingredients : Centella Asiatica Extract, Artemisia Vulgaris Extract, Sodium Hyaluronate
Texture : Watery and lightweight texture
Benefits : Soothing, Calming
<Glow Serum : Propolis + Niacinamide>
Solution : Propolis Extract 60% + Niacinamide 2%
Notable ingredients : Betaine Salicylate (BHA), Tamanu Oil, Tea Tree Extract
Texture : Honey-like texture
Benefits : Anti-acne, Anti-inflammation
<Glow Deep Serum : Rice + Alpha-Arbutin>
Solution : Rice bran water 68% + Alpha-Arbutin 2%
Notable ingredients : Glycerin, Niacinamide, Soybean Seed Extract, Barley Extract, Rice Extract, Sesame Extract
Texture : Watery and lightweight texture
Benefits : Anti-pigmentation, Brightening
<Revive Serum : Ginseng + Snail Mucin>
Solution : Ginseng Root Water 63% + Snail Mucin 3%
Notable ingredients : Ginseng Root Extract, Adenosine, Matsutake Extract
Texture : Lightweight, Mucin-like texture
Benefits : Anti-wrinkle, Anti-pigmentation
How To use
Apply 2-3 drops of serum onto the face. Pat gently to aid absorption.
Ingredient
Check individual Product
Fast Delivery
1-2 working Days to UAE and up to 7 days to other countries
Couldn't load pickup availability

Hanbang Serum Discovery Kit
- Regular price
-
Dhs. 80.00 AED - Regular price
-
Dhs. 100.00 AED - Sale price
-
Dhs. 80.00 AED

